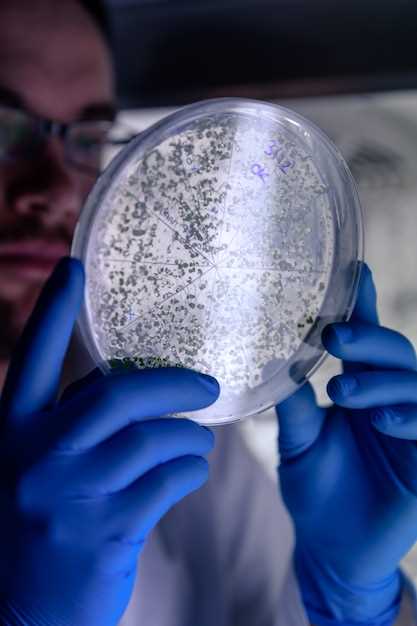
Overview of Atorvastatin

Discovery of atorvastatin
2026-02-07The discovery of atorvastatin marked a major breakthrough in the field of cardiovascular medicine. Developed by scientists in the late 20th century, atorvastatin has since become one of the most widely prescribed medications for the treatment of high cholesterol and prevention of cardiovascular diseases.
Atorvastatin is a potent cholesterol-lowering medication known as a statin. It works by inhibiting the enzyme HMG-CoA reductase, which is responsible for the production of cholesterol in the liver. By reducing the production of cholesterol, atorvastatin helps to lower the levels of LDL (low-density lipoprotein) cholesterol in the blood, also known as "bad" cholesterol.
In addition to its cholesterol-lowering effects, atorvastatin has been shown to have anti-inflammatory and antioxidant properties, which may further contribute to its beneficial effects on cardiovascular health.
Since its discovery, atorvastatin has been extensively studied and proven to be highly effective in reducing the risk of heart attacks, strokes, and other cardiovascular events. It is often prescribed to patients with high cholesterol levels, as well as those with existing heart conditions, to help improve their overall cardiovascular health and reduce the risk of future complications.
Consult your healthcare provider to see if atorvastatin may be right for you.
Overview of Atorvastatin
Atorvastatin is a medication that belongs to a group of drugs known as statins. It is primarily used to lower cholesterol levels and reduce the risk of heart disease. This medication is commonly prescribed by doctors to patients who have high levels of LDL cholesterol or who are at risk of developing cardiovascular complications.
Discovery and Identification of Compound
The discovery and identification of atorvastatin began in the late 1970s when researchers were actively studying the pathways involved in cholesterol synthesis. Through extensive research and experimentation, a compound with promising cholesterol-lowering properties was identified.
Further development and refinement of the compound led to the creation of atorvastatin. It was found to be highly effective in inhibiting an enzyme called HMG-CoA reductase, which plays a crucial role in cholesterol production in the body.
Mechanism of Action
Atorvastatin works by blocking the action of HMG-CoA reductase, an enzyme involved in the production of cholesterol in the liver. By inhibiting this enzyme, atorvastatin helps to reduce the amount of cholesterol that is synthesized, leading to lower LDL cholesterol levels in the bloodstream.
Additionally, atorvastatin has been found to increase the number of LDL receptors on the surface of liver cells. These receptors play a crucial role in removing LDL cholesterol from the bloodstream, further contributing to the reduction of cholesterol levels.
Overall, the mechanism of action of atorvastatin helps to effectively lower LDL cholesterol levels, which is crucial in reducing the risk of cardiovascular diseases.
Use and Benefits
Atorvastatin is mainly prescribed for individuals who have elevated levels of LDL cholesterol or who are at risk of developing heart disease. It is commonly used as an adjunct to a healthy lifestyle, including a balanced diet and regular exercise.
The use of atorvastatin has been associated with a range of benefits, including:
- Lowering LDL cholesterol levels
- Increasing HDL cholesterol levels
- Reducing the risk of heart attack and stroke
- Preventing the progression of atherosclerosis
- Improving overall heart health
It is important to note that atorvastatin should always be used under the guidance and supervision of a healthcare professional, as it may have potential side effects and interactions with other medications.
Discovery
The discovery of atorvastatin was a significant breakthrough in the field of pharmaceutical research. Scientists and researchers dedicated extensive time and effort into identifying and developing this compound, which has since become a widely prescribed medication for managing cholesterol levels.
Identification of Compound
The journey to discovering atorvastatin began with the identification of a promising compound that showed potential in reducing cholesterol levels. Through rigorous testing and analysis, researchers were able to isolate and identify atorvastatin as a potent inhibitor of HMG-CoA reductase, an enzyme crucial for cholesterol synthesis.
This identification marked a milestone in the development of atorvastatin, as it laid the foundation for further research and understanding of its mechanisms of action.
Research and Development
Once atorvastatin was identified, extensive research and development efforts were initiated to explore its therapeutic effects and potential benefits. Scientists conducted numerous experiments and clinical trials to evaluate the safety and efficacy of atorvastatin in reducing cholesterol levels and preventing cardiovascular events.
Over the years, the research and development process led to a deep understanding of the compound's pharmacokinetics, pharmacodynamics, and overall mechanism of action. This knowledge helped pave the way for atorvastatin to become one of the most widely prescribed statin medications.
Researchers also investigated the various formulations and dosages of atorvastatin to optimize its therapeutic potential and ensure its safety for long-term use.
- Extensive research and development efforts were conducted
- Clinical trials evaluated safety and efficacy
- Pharmacokinetics and pharmacodynamics were studied
- Formulations and dosages were optimized
Overall, the research and development phase played a crucial role in establishing atorvastatin as a widely accepted and trusted medication for managing cholesterol levels and reducing the risk of cardiovascular events.
Identification of compound
Atorvastatin, also known as Lipitor, was discovered in the early 1980s by Dr. Bruce Roth and his team at Warner-Lambert Parke-Davis. The researchers were investigating the role of cholesterol in cardiovascular diseases and aimed to develop a drug that could effectively lower cholesterol levels in the body.
Through a series of experiments and tests, the scientists were able to identify a compound that showed potential in inhibiting an enzyme called HMG-CoA reductase. This enzyme plays a crucial role in the production of cholesterol in the body.
The compound, which was later named atorvastatin, exhibited strong inhibitory effects on HMG-CoA reductase, effectively reducing the production of cholesterol in cells. This discovery marked a significant breakthrough in the field of cardiovascular medicine, as it provided a promising new approach to managing high cholesterol levels.
| Discovery: | Early 1980s |
| Compound: | Atorvastatin |
| Enzyme targeted: | HMG-CoA reductase |
The identification of atorvastatin as an effective HMG-CoA reductase inhibitor paved the way for further research and development. Scientists worked on refining the compound and conducting extensive clinical trials to assess its safety and efficacy.
Today, atorvastatin is widely recognized as one of the most effective medications for reducing LDL cholesterol and preventing cardiovascular diseases. It continues to be an essential tool in the fight against high cholesterol, helping millions of people around the world achieve healthier cholesterol levels and reduce their risk of heart disease.
Research and development
During the research and development process, scientists conducted extensive studies to understand the mechanism of action of atorvastatin and its potential benefits. They aimed to create a medication that could effectively lower cholesterol levels and reduce the risk of cardiovascular diseases.
Mechanism of action
Atorvastatin belongs to a class of drugs known as statins, which work by inhibiting the enzyme HMG-CoA reductase. This enzyme is responsible for the production of cholesterol in the body. By blocking this enzyme, atorvastatin helps to reduce the amount of cholesterol that is synthesized, leading to lower overall cholesterol levels.
Inhibition of HMG-CoA reductase
By inhibiting HMG-CoA reductase, atorvastatin effectively reduces the production of cholesterol in the liver. This leads to a decrease in LDL cholesterol, often referred to as "bad" cholesterol, as well as other harmful fats known as triglycerides. Additionally, atorvastatin has been shown to increase levels of HDL cholesterol, or "good" cholesterol.
Effects on cholesterol levels
Atorvastatin has been proven to significantly reduce LDL cholesterol levels, which is a major risk factor for the development of heart disease and stroke. By lowering LDL cholesterol, atorvastatin helps to prevent the buildup of plaque in the arteries, leading to improved blood flow and reduced risk of cardiovascular events.
Benefits
In addition to its cholesterol-lowering effects, atorvastatin has been shown to have other benefits. It has been found to reduce inflammation in the arteries, improve endothelial function, and stabilize existing plaque. These effects can further reduce the risk of cardiovascular events and promote overall heart health.
Mechanism of action

The mechanism of action of atorvastatin involves the inhibition of HMG-CoA reductase, which is an enzyme responsible for the production of cholesterol in the body. By inhibiting this enzyme, atorvastatin helps to lower cholesterol levels in the bloodstream.
HMG-CoA reductase:
Atorvastatin works by blocking the action of HMG-CoA reductase, an enzyme that plays a crucial role in the production of cholesterol in the liver. By inhibiting this enzyme, atorvastatin reduces the amount of cholesterol that is produced, leading to lower cholesterol levels in the bloodstream.
Lowering cholesterol:
When cholesterol levels are high, it can lead to the development of plaques in the arteries, which can increase the risk of heart disease and stroke. By reducing cholesterol levels, atorvastatin helps to prevent the formation of these plaques and reduces the risk of cardiovascular events.
Additional benefits:
In addition to lowering cholesterol, atorvastatin has been shown to have other beneficial effects on cardiovascular health. It can increase the levels of high-density lipoprotein (HDL) cholesterol, which is considered to be "good" cholesterol, and decrease the levels of low-density lipoprotein (LDL) cholesterol, which is considered to be "bad" cholesterol. Atorvastatin can also reduce inflammation and improve the function of the endothelium, the inner lining of blood vessels, which helps to promote healthy blood flow.
Overall, the mechanism of action of atorvastatin involves the inhibition of HMG-CoA reductase, leading to lower cholesterol levels and reducing the risk of cardiovascular events. It offers multiple benefits for cardiovascular health and is a commonly prescribed medication for managing high cholesterol levels.
Inhibition of HMG-CoA reductase
The key mechanism of action of atorvastatin is the inhibition of HMG-CoA reductase, an enzyme involved in the synthesis of cholesterol in the liver. By inhibiting this enzyme, atorvastatin reduces the production of cholesterol, leading to lower levels of LDL (bad) cholesterol in the bloodstream.
High levels of LDL cholesterol are a major risk factor for cardiovascular diseases, such as heart attack or stroke. By inhibiting HMG-CoA reductase, atorvastatin helps to lower LDL cholesterol and therefore reduce the risk of these serious health conditions.
Moreover, atorvastatin has been shown to increase the levels of HDL (good) cholesterol in the bloodstream. HDL cholesterol helps remove excess cholesterol from the arteries, preventing plaque buildup and reducing the risk of atherosclerosis.
Overall, atorvastatin's inhibition of HMG-CoA reductase has a profound impact on cholesterol levels, leading to improved cardiovascular health. It is a clinically proven and highly effective treatment option for individuals with high cholesterol levels, helping them to achieve better lipid profiles and reduce their risk of cardiovascular events.
Effects on cholesterol levels
Atorvastatin, the active ingredient in our medication, has been proven to significantly lower cholesterol levels in the body. It achieves this by inhibiting the enzyme HMG-CoA reductase, which is responsible for the production of cholesterol in the liver. By blocking this enzyme, atorvastatin effectively reduces the amount of cholesterol that is synthesized in the body.
Studies have shown that atorvastatin not only lowers LDL cholesterol, commonly known as "bad" cholesterol, but also increases HDL cholesterol, which is considered the "good" cholesterol. This dual action helps to restore a healthy balance of cholesterol levels in the body.
By reducing cholesterol levels, atorvastatin can greatly reduce the risk of heart disease and other cardiovascular conditions. High cholesterol is a major risk factor for these diseases, and by effectively managing cholesterol levels, atorvastatin helps to prevent the buildup of plaque in the arteries and reduces the risk of blockages.
It is important to note that atorvastatin is most effective when used in conjunction with a healthy lifestyle, including a balanced diet and regular exercise. However, for many individuals, atorvastatin can be a crucial component in managing cholesterol levels and reducing the risk of heart disease.
Benefits
The benefits of atorvastatin are numerous and significant. This medication has been proven to effectively lower cholesterol levels, particularly low-density lipoprotein (LDL) cholesterol, commonly known as "bad" cholesterol. By inhibiting the enzyme HMG-CoA reductase, atorvastatin helps prevent the production of cholesterol in the liver, thereby reducing its presence in the bloodstream.
Lowering cholesterol levels with atorvastatin can lead to a range of positive health outcomes. Studies have shown that atorvastatin can significantly reduce the risk of cardiovascular events, such as heart attacks and strokes, in individuals with high cholesterol levels. It also has the potential to slow down the progression of atherosclerosis, a condition characterized by the buildup of plaque in the arteries.
Furthermore, atorvastatin has been found to have anti-inflammatory properties, which may contribute to its cardioprotective effects. It is believed that the medication can help reduce inflammation in the blood vessels, thereby improving their function and reducing the risk of cardiovascular complications.
In addition to its cardiovascular benefits, atorvastatin has also shown potential in other areas of health. Some studies suggest that it may have a positive impact on cognitive function, as it has been associated with a reduced risk of dementia and Alzheimer's disease. It may also have protective effects on the liver and kidneys, although further research is needed to fully understand these potential benefits.
Overall, atorvastatin is a widely prescribed medication that offers a range of benefits for individuals with high cholesterol levels. By effectively lowering cholesterol and reducing the risk of cardiovascular events, it can help improve overall health and well-being.